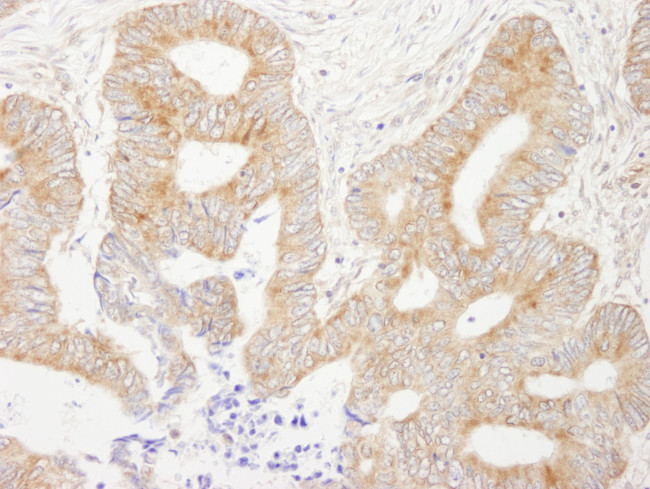
AKAP1 Antibody in Immunohistochemistry (Paraffin) (IHC (P))

Search
Bethyl Laboratories
AKAP1 Polyclonal Antibody
{{$productOrderCtrl.translations['antibody.pdp.commerceCard.promotion.promotions']}}
{{$productOrderCtrl.translations['antibody.pdp.commerceCard.promotion.viewpromo']}}
{{$productOrderCtrl.translations['antibody.pdp.commerceCard.promotion.promocode']}}: {{promo.promoCode}} {{promo.promoTitle}} {{promo.promoDescription}}. {{$productOrderCtrl.translations['antibody.pdp.commerceCard.promotion.learnmore']}}


Please note: We are reviewing Western blot images included in the antibody testing data in our catalog, including those provided by third parties. Unless expressly labeled or annotated as “raw-unedited”, Western blot images included in the antibody testing data in our catalog may have been edited, optimized or otherwise adjusted for presentation.
产品信息
A301-380A
种属反应
宿主/亚型
分类
类型
抗原
偶联物
形式
浓度
规格
纯化类型
保存液
内含物
保存条件
运输条件
产品详细信息
The recommended shelf life for this product is 1 year from date of receipt.
Application Note: For IHC, epitope retrieval with citrate buffer pH 6.0 is recommended for FFPE tissue sections.
靶标信息
This gene encodes an enzyme which reversibly catalyzes the phosphorolysis of purine nucleosides. The enzyme is trimeric, containing three identical subunits. Mutations which result in nucleoside phosphorylase deficiency result in defective T-cell (cell-mediated) immunity but can also affect B-cell immunity and antibody responses. Neurologic disorders may also be apparent in patients with immune defects. A known polymorphism at aa position 51 that does not affect enzyme activity has been described. A pseudogene has been identified on chromosome 2.
仅用于科研。不用于诊断过程。未经明确授权不得转售。
篇参考文献 (0)
生物信息学
蛋白别名: A-kinase anchor protein 1, mitochondrial; A-kinase anchor protein 149 kDa; AKAP 149; D-AKAP-1; Dual specificity A-kinase-anchoring protein 1; PRKA1; Protein kinase A-anchoring protein 1; S-AKAP84; spermatid A-kinase; Spermatid A-kinase anchor protein 84
基因别名: AKAP1; AKAP149; PRKA1
Entrez Gene ID: (Human) 8165